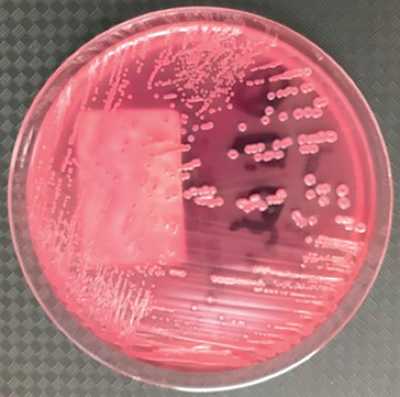
PML Microbiologicals # 121304

- All Products
- General
- PML Microbiologicals # 121304
PML Microbiologicals # 121304
ESCHERICHIA COLI CLTRE HZ
SKU Number: MAP01047875
Ships within 24 Hours
Brand: PML Microbiologicals
$ 52.10 $ 52.10
Log in or create an account to proceed with checkout.
How Can We Help? Fast answers on bulk discounts, same-day shipping, and other questions for our team
Request Product Info
PML Microbiologicals # 121304 - General
PML Microbiologicals # 121304 ESCHERICHIA COLI CLTRE HZ in General, available with fast delivery and best prices. Order today!
Let Us Know How We Can Assist
Please enter your contact information and details of
your request below.
One of our dedicated team members will be in touch shortly
×

